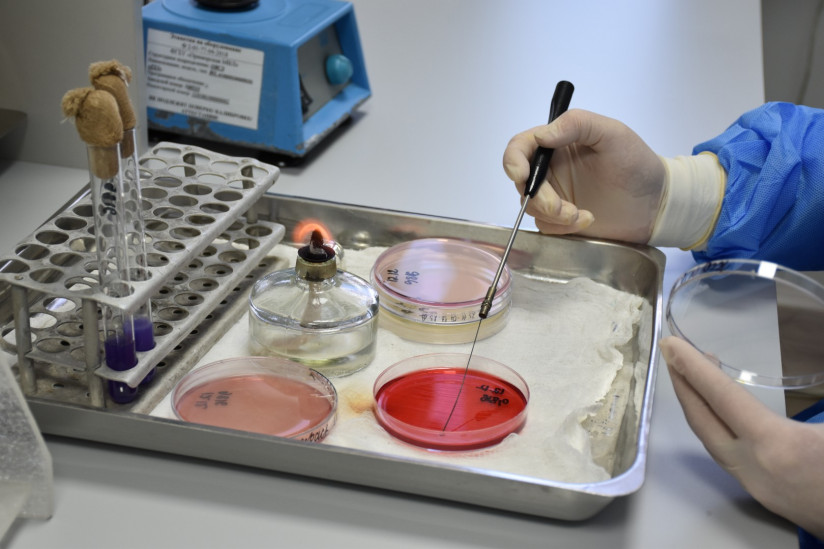
примкур

Специалистами Приморского филиала подведомственного Россельхознадзору ФГБУ «НЦБРСП» установлена сальмонелла в партии утиных ножек из КНР и подтверждено наличие листерии в партии импортного мяса курицы.
ФГБУ «Национальный центр безопасности продукции водного промысла и аквакультуры» в сообщении, с которым ознакомилась sfera.fm, указывает, что два разных заражения были обнаружены в партиях импортной птицы, исследованных в мае.
Первое исследование проводилось с пробами, отобранными от партии импортных замороженных ножек цыплёнка-бройлера общим весом 27 тонн. Согласно протоколу исследований от 16 мая в продукции выявлены опасные бактерии листерии. Пробы для проведения исследования были отобраны инспекторами Приморского межрегионального управления Россельхознадзора в рамках выполнения государственного задания по контролю импортной продукции на складе временного хранения во Владивостоке.
Согласно протоколу испытаний от 19 мая в партии утиных ножек, поставленных из КНР, выявлено наличие бактерий рода сальмонелла, что является нарушением требований технических регламентов «О безопасности пищевой продукции» и «О безопасности мяса птицы и продукции его переработки». Как отметили в ведомстве, сальмонеллы хорошо сохраняются в мясе, даже замороженном, и способны в нем активно размножаться. Губительно на сальмонеллы действует только тщательная термическая обработка.
Информация о заражениях донесена до ответственных лиц, а также внесена в автоматизированную систему (АС) в области ветеринарии «Веста».
Ранее sfera.fm сообщала, что ГК «Агропромкомплектация» начнет оказывать услуги по дезинфекции сторонним организациям.
Арсений Протасов, sfera.fm












